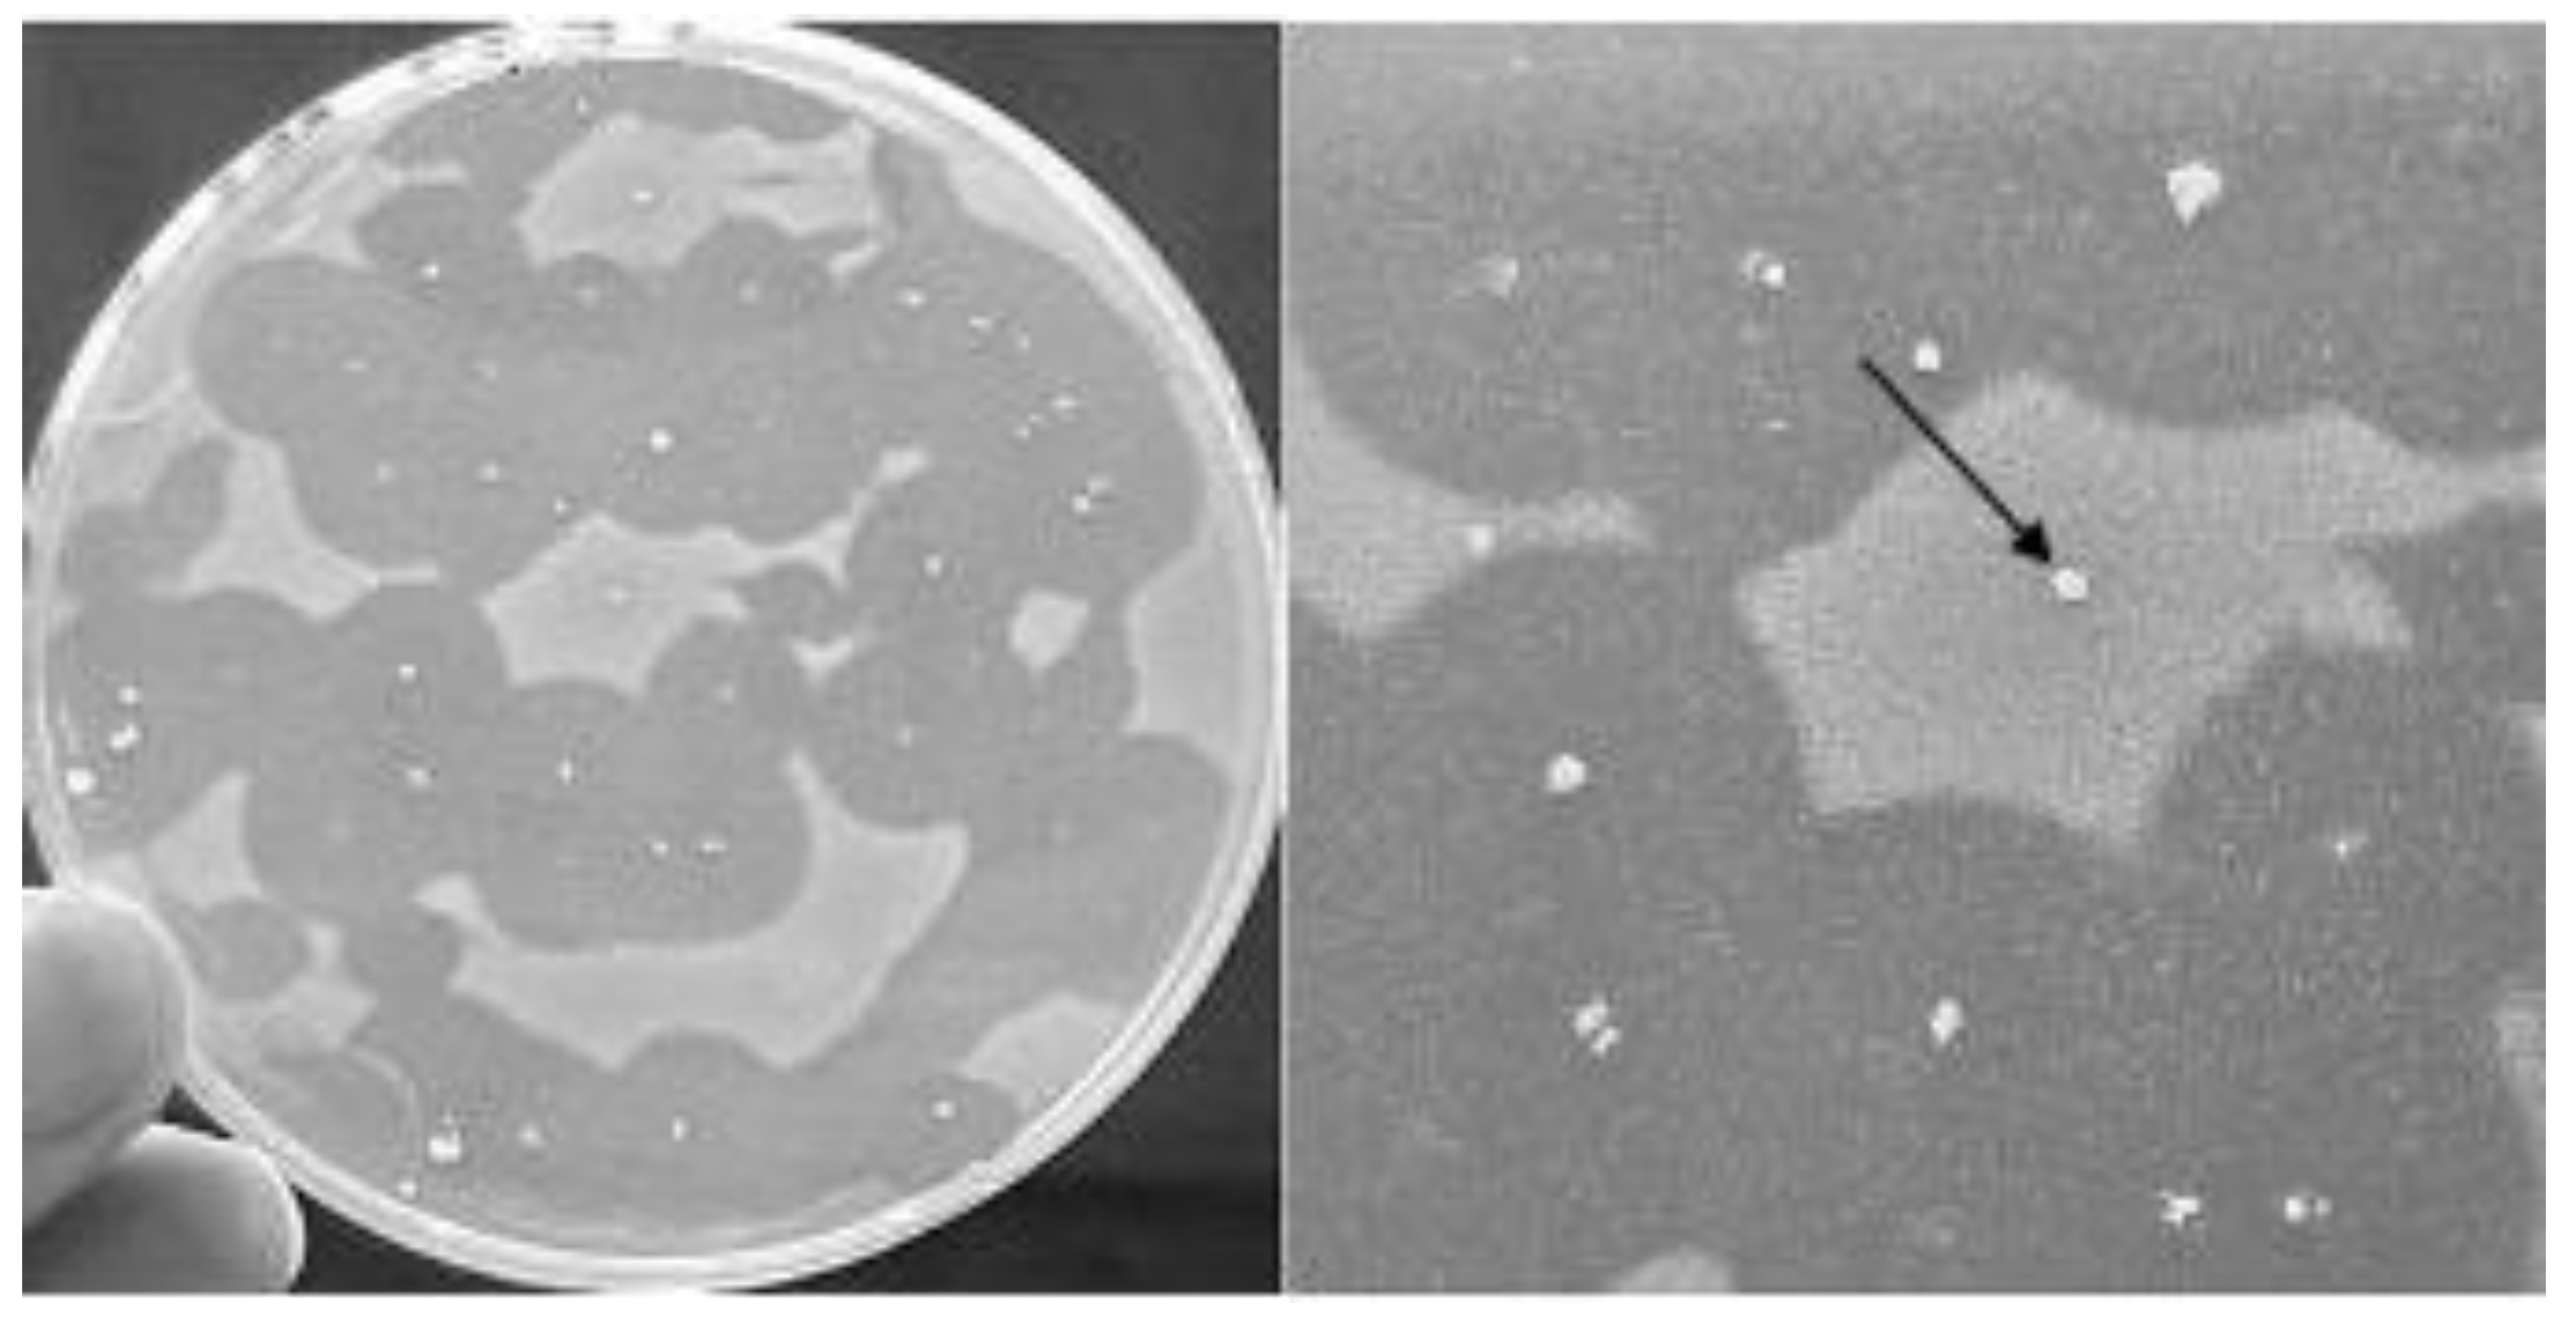
Foods 09 01757 g003 Foods 09 01757 g003

Antilisterial Activity of Bacteriocins Produced by Lactic Bacteria Isolated from Dairy Products
Abstract
1. Introduction
2. Materials and Methods
2.1. Bacterial Strains
2.2. Antibacterial Activity Evaluation
2.3. Kinetic of Growth, Bacteriocin Biosynthesis and Molecular Size
2.4. Sensitivity to Chemical–Physical Parameters
2.5. Plasmid Curing and Transferability
3. Results
3.1. Antibacterial Activity Evaluation
3.2. Growth Kinetics, Bacteriocin Biosynthesis and Molecular Size
3.3. Sensitivity to Chemical-Physical Parameters
3.4. Plasmid Curing and Transferability
4. Discussion
5. Conclusions
Author Contributions
Funding
Conflicts of Interest
References
- Gurtler, J.B.; Rivera, R.B.; Zhang, H.Q.; Sommers, C.H. Behavior of Avirulentyersinia pestisin liquid whole egg as affected by storage temperature, antimicrobials and thermal pasteurization. J. Food Saf. 2010, 30, 537–557. [Google Scholar] [CrossRef]
- Pilet, M.-F.; Leroi, F. Applications of protective cultures, bacteriocins and bacteriophages in fresh seafood and seafood products. In Protective Cultures, Antimicrobial Metabolites and Bacteriophages for Food and Beverage Biopreservation; Woodhead Publishing Limited: Cambridge, UK, 2011; pp. 324–347. [Google Scholar] [CrossRef]
- Keshri, J.; Krouptiski, Y.; Abu-Fani, L.; Achmon, Y.; Bauer, T.S.; Zarka, O.; Maler, I.; Pinto, R.; Sela, S. Dynamics of bacterial communities in alfalfa and mung bean sprouts during refrigerated conditions. Food Microbiol. 2019, 84, 103261. [Google Scholar] [CrossRef] [PubMed]
- Berge, A.C.; Baars, T. Raw milk producers with high levels of hygiene and safety. Epidemiol. Infect. 2020, 148, e14. [Google Scholar] [CrossRef] [PubMed]
- Batz, M.B.; Hoffmann, S.; Morris, J.G. Ranking the Disease Burden of 14 Pathogens in Food Sources in the United States Using Attribution Data from Outbreak Investigations and Expert Elicitation†. J. Food Prot. 2012, 75, 1278–1291. [Google Scholar] [CrossRef] [PubMed]
- Casaburi, A.; Piombino, P.; Nychas, G.-J.; Villani, F.; Ercolini, D. Bacterial populations and the volatilome associated to meat spoilage. Food Microbiol. 2015, 45, 83–102. [Google Scholar] [CrossRef] [PubMed]
- Wang, G.-Y.; Wang, H.-H.; Han, Y.-W.; Xing, T.; Ye, K.-P.; Xu, X.; Zhou, G. Evaluation of the spoilage potential of bacteria isolated from chilled chicken in vitro and in situ. Food Microbiol. 2017, 63, 139–146. [Google Scholar] [CrossRef]
- Doulgeraki, A.I.; Ercolini, D.; Villani, F.; Nychas, G.J.E. Spoilage microbiota associated to the storage of raw meat in different conditions. Int. J. Food Microbiol. 2012, 157, 130–141. [Google Scholar] [CrossRef]
- Ghanbari, M.; Jami, M. Lactic Acid Bacteria and Their Bacteriocins: A Promising Approach to Seafood Biopreservation. In Lactic Acid Bacteria—R & D for Food, Health and Livestock Purposes; IntechOpen: London, UK, 2013. [Google Scholar]
- Giraffa, G.; Chanishvili, N.; Widyastuti, Y. Importance of lactobacilli in food and feed biotechnology. Res. Microbiol. 2010, 161, 480–487. [Google Scholar] [CrossRef]
- Alves, V.F.; Martinez, R.; Lavrador, M.; De Martinis, E. Antilisterial activity of lactic acid bacteria inoculated on cooked ham. Meat Sci. 2006, 74, 623–627. [Google Scholar] [CrossRef]
- Barile, M.; Mormile, A.; Mercogliano, R.; Murru, N. Antilisterial activity of Lactic Acid Bacteria isolated from gilthead breams and sea basses fillets packaged map against primitive strains of Listeria monocytogenes. Ital. J. Food Saf. 2013, 1, 23–28. [Google Scholar] [CrossRef]
- Marco, M.L.; Heeney, D.; Binda, S.; Cifelli, C.J.; Cotter, P.D.; Foligné, B.; Gänzle, M.; Kort, R.; Pasin, G.; Pihlanto, A.; et al. Health benefits of fermented foods: Microbiota and beyond. Curr. Opin. Biotechnol. 2017, 44, 94–102. [Google Scholar] [CrossRef] [PubMed]
- Macori, G.; Cotter, P.D. Novel insights into the microbiology of fermented dairy foods. Curr. Opin. Biotechnol. 2018, 49, 172–178. [Google Scholar] [CrossRef] [PubMed]
- Giraffa, G. Functionality of enterococci in dairy products. Int. J. Food Microbiol. 2003, 88, 215–222. [Google Scholar] [CrossRef]
- Moreno, M.F.; Sarantinopoulos, P.; Tsakalidou, E.; De Vuyst, L. The role and application of enterococci in food and health. Int. J. Food Microbiol. 2006, 106, 1–24. [Google Scholar] [CrossRef] [PubMed]
- Wu, C.; Huang, J.; Zhou, R. Genomics of lactic acid bacteria: Current status and potential applications. Crit. Rev. Microbiol. 2017, 43, 393–404. [Google Scholar] [CrossRef] [PubMed]
- Messi, P.; Bondi, M.; Sabia, C.; Battini, R.; Manicardi, G. Detection and preliminary characterization of a bacteriocin (plantaricin 35d) produced by a Lactobacillus plantarum strain. Int. J. Food Microbiol. 2001, 64, 193–198. [Google Scholar] [CrossRef]
- Sabia, C.; Manicardi, G.; Messi, P.; de Niederhausern, S.; Bondi, M. Enterocin 416K1, an antilisterial bacteriocin produced by Enterococcus casseliflavus IM 416K1 isolated from Italian sausages. Int. J. Food Microbiol. 2002, 75, 163–170. [Google Scholar] [CrossRef]
- Anacarso, I.; Messi, P.; Condò, C.; Iseppi, R.; Bondi, M.; Sabia, C.; De Niederhäusern, S. A bacteriocin-like substance produced from Lactobacillus pentosus 39 is a natural antagonist for the control of Aeromonas hydrophila and Listeria monocytogenes in fresh salmon fillets. LWT 2014, 55, 604–611. [Google Scholar] [CrossRef]
- Iseppi, R.; Stefani, S.; De Niederhausern, S.; Bondi, M.; Sabia, C.; Messi, P. Characterization of Anti-Listeria monocytogenes Properties of two Bacteriocin-Producing Enterococcus mundtii Isolated from Fresh Fish and Seafood. Curr. Microbiol. 2019, 76, 1010–1019. [Google Scholar] [CrossRef]
- Castro, H.; Jaakkonen, A.; Hakkinen, M.; Korkeala, H.; Lindström, M. Occurrence, Persistence, and Contamination Routes of Listeria monocytogenes Genotypes on Three Finnish Dairy Cattle Farms: A Longitudinal Study. Appl. Environ. Microbiol. 2017, 84, e02000-17. [Google Scholar] [CrossRef]
- Lundén, J.; Tolvanen, R.; Korkeala, H. Human Listeriosis Outbreaks Linked to Dairy Products in Europe. J. Dairy Sci. 2004, 87, E6–E12. [Google Scholar] [CrossRef]
- International Organization for Standardizatio, ISO 7889, Yoghurt. Counting of Characteristic Microorganisms. Method of Counting Colonies of Microorganisms after Incubation at a Temperature of 37 °C. 2 April 2015. Available online: https://www.iso.org/standard/31880.html (accessed on 12 December 2019).
- IDF. Guideline for the enumeration of bifidobacteria in fermented dairy products. Bull. Int. Dairy Fed. 1990, 340, 19–23. [Google Scholar]
- Nacef, M.; Chevalier, M.; Chollet, S.; Drider, D.; Flahaut, C. MALDI-TOF mass spectrometry for the identification of lactic acid bacteria isolated from a French cheese: The Maroilles. Int. J. Food Microbiol. 2017, 247, 2–8. [Google Scholar] [CrossRef] [PubMed]
- Kékessy, D.A.; Piguet, J.D. New Method for Detecting Bacteriocin Production. Appl. Microbiol. 1970, 20, 282–283. [Google Scholar] [CrossRef] [PubMed]
- Rogers, A.M.; Montville, T.J. Improved agar diffusion assay for nisin quantification. Food Biotechnol. 1991, 5, 161–168. [Google Scholar] [CrossRef]
- Mayr-Harting, A.; Hedges, A.; Berkeley, R. Chapter VII Methods for Studying Bacteriocins. In Methods in Microbiology; Elsevier BV: Amsterdam, The Netherlands, 1972; Volume 7, pp. 315–422. [Google Scholar]
- O’Sullivan, D.J.; Klaenhammer, T.R. Rapid Mini-Prep Isolation of High-Quality Plasmid DNA from Lactococcus and Lactobacillus spp. Appl. Environ. Microbiol. 1993, 59, 2730–2733. [Google Scholar] [CrossRef] [PubMed]
- Macrina, F.L.; Kopecko, D.J.; Jones, K.R.; Ayers, D.J.; McCowen, S.M. A multiple plasmid-containing Escherichia coli strain: Convenient source of size reference plasmid molecules. Plasmid 1978, 1, 417–420. [Google Scholar] [CrossRef]
- Jacob, A.E.; Hobbs, S.J. Conjugal Transfer of Plasmid-Borne Multiple Antibiotic Resistance in Streptococcus faecalis var. zymogenes. J. Bacteriol. 1974, 117, 360–372. [Google Scholar] [CrossRef]
- Klaenhammer, T.R. Genetics of bacteriocins produced by lactic acid bacteria. FEMS Microbiol. Rev. 1993, 12, 39–85. [Google Scholar] [CrossRef]
- Floriano, B.; Ruiz-Barba, J.L.; Jiménez-Díaz, R. Purification and Genetic Characterization of Enterocin I from Enterococcus faecium 6T1a, a Novel Antilisterial Plasmid-Encoded Bacteriocin Which Does Not Belong to the Pediocin Family of Bacteriocins. Appl. Environ. Microbiol. 1998, 64, 4883–4890. [Google Scholar] [CrossRef]
- Balla, E.; Dicks, L.M.T.; Du Toit, M.; Van Der Merwe, M.J.; Holzapfel, W.H. Characterization and Cloning of the Genes Encoding Enterocin 1071A and Enterocin 1071B, Two Antimicrobial Peptides Produced by Enterococcus faecalis BFE 1071. Appl. Environ. Microbiol. 2000, 66, 1298–1304. [Google Scholar] [CrossRef] [PubMed]
- European Food Safety Authority; European Centre for Disease Prevention and Control. Multi-country outbreak of Listeria monocytogenes serogroup IVb, multi-locus sequence type 6, infections linked to frozen corn and possibly to other frozen vegetables—First update. EFSA Support. Publ. 2018, 15, 1448E. [Google Scholar] [CrossRef]
- European Union. RASFF—Food and Feed Safety Alerts. 14 December 2019. Available online: https://ec.europa.eu/food/safety/rasff_en (accessed on 12 December 2019).
- Maldonado, A.; Ruiz-Barba, J.L.; Jiménez-Díaz, R. Production of plantaricin NC8 by Lactobacillus plantarum NC8 is induced in the presence of different types of gram-positive bacteria. Arch. Microbiol. 2004, 181, 8–16. [Google Scholar] [CrossRef] [PubMed]
- Sun, Z.; Wang, X.; Zhang, X.; Wu, H.; Zou, Y.; Li, P.; Sun, C.; Xu, W.; Liu, F.; Wang, D. Class III bacteriocin Helveticin-M causes sublethal damage on target cells through impairment of cell wall and membrane. J. Ind. Microbiol. Biotechnol. 2018, 45, 213–227. [Google Scholar] [CrossRef] [PubMed]
- Makrides, S.C. Strategies for achieving high-level expression of genes in Escherichia coli. Microbiol. Rev. 1996, 60, 512–538. [Google Scholar] [CrossRef] [PubMed]
- Rodríguez, J.M.; I Martínez, M.; Horn, N.; Dodd, H.M. Heterologous production of bacteriocins by lactic acid bacteria. Int. J. Food Microbiol. 2003, 80, 101–116. [Google Scholar] [CrossRef]
- Perales-Adán, J.; Rubiño, S.; Martínez-Bueno, M.; Valdivia, E.; Montalbán-López, M.; Cebrián, R.; Maqueda, M. LAB Bacteriocins Controlling the Food Isolated (Drug-Resistant) Staphylococci. Front. Microbiol. 2018, 9, 1143. [Google Scholar] [CrossRef]
- Ennahar, S.; Deschamps, N. Anti-Listeria effect of enterocin A, produced by cheese-isolated Enterococcus faecium EFM01, relative to other bacteriocins from lactic acid bacteria. J. Appl. Microbiol. 2000, 88, 449–457. [Google Scholar] [CrossRef]

| Producers * | |||||
|---|---|---|---|---|---|
| Indicators | E21 | E23 | E24 | L21 | B23 |
| Enterococcus faecalis E11 | - | ++ | - | ++ | ++ |
| Enterococcus casseliflavus E26 | - | ++ | - | ++ | - |
| Bifidobacterium spp. B22 | - | + | - | + | + |
| Lactcoccus lactis L23 | - | ++ | - | - | ++ |
| Lactcoccus spp. L14 | - | ++ | - | ++ | ++ |
| Listeria monocytogene NCTC 10888 | - | +++ | - | + | + |
| Listeria monocitogenes 4C | - | ++ | - | + | + |
| Listeria monocitogenes 25C | - | +++ | - | + | - |
| Listeria monocytogenes 30C | - | ++ | - | + | + |
Publisher’s Note: MDPI stays neutral with regard to jurisdictional claims in published maps and institutional affiliations. |
© 2020 by the authors. Licensee MDPI, Basel, Switzerland. This article is an open access article distributed under the terms and conditions of the Creative Commons Attribution (CC BY) license (http://creativecommons.org/licenses/by/4.0/).
Share and Cite
Niederhäusern, S.d.; Camellini, S.; Sabia, C.; Iseppi, R.; Bondi, M.; Messi, P. Antilisterial Activity of Bacteriocins Produced by Lactic Bacteria Isolated from Dairy Products. Foods 2020, 9, 1757. https://doi.org/10.3390/foods9121757
Niederhäusern Sd, Camellini S, Sabia C, Iseppi R, Bondi M, Messi P. Antilisterial Activity of Bacteriocins Produced by Lactic Bacteria Isolated from Dairy Products. Foods. 2020; 9(12):1757. https://doi.org/10.3390/foods9121757
Chicago/Turabian StyleNiederhäusern, Simona de, Stefania Camellini, Carla Sabia, Ramona Iseppi, Moreno Bondi, and Patrizia Messi. 2020. "Antilisterial Activity of Bacteriocins Produced by Lactic Bacteria Isolated from Dairy Products" Foods 9, no. 12: 1757. https://doi.org/10.3390/foods9121757
APA StyleNiederhäusern, S. d., Camellini, S., Sabia, C., Iseppi, R., Bondi, M., & Messi, P. (2020). Antilisterial Activity of Bacteriocins Produced by Lactic Bacteria Isolated from Dairy Products. Foods, 9(12), 1757. https://doi.org/10.3390/foods9121757

